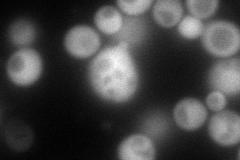
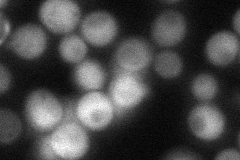
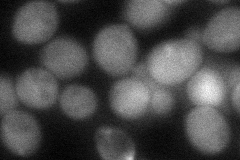
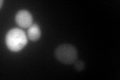

View description
Phospholipid hydroperoxide glutathione peroxidase induced by glucose starvation that protects cells from phospholipid hydroperoxides and nonphospholipid peroxides during oxidative stress
Localization:
Intensity:
Fold change:
Significance:
-
C’ GFP library in SD

cytosol72.2 -
N' NOP1pr-GFP in SD
cytosol193.699 -
N' TEF2pr-mCherry in SD

cytosol100.98 -
N' NATIVEpr-GFP in SD
cytosol59.2652 -
N' TEF2pr-VC and Cyto-VN in SD
cytosol57.3701 -
C’ GFP library in SD+DTT
cytosol85.121.17No -
C’ GFP library in SD+H2O2

cytosol227.73.15Yes -
C’ GFP library in Starvation Media

cytosol106.411.47Yes -
C’ GFP library on the background of Pup2-DaMP

cytosol -
C’ GFP library on the background of CCT mutant

cytosol70.63840.978196No
